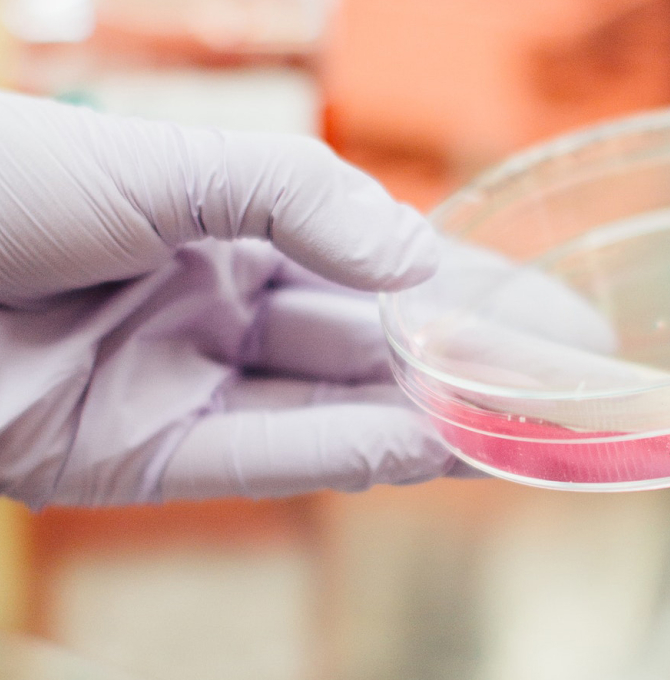

Kampf gegen den Krebs
Forschungsergebnisse schneller für die Menschen nutzen
In der Bundestagsdebatte zu verschiedenen Forschungsberichten der Bundesregierung waren sich die Vertreter von CDU und CSU einig in der Forderung, dass der Transfer von der Wissenschaft in die Gesellschaft noch weiter verbessert werden muss. Eine besonders wichtige Rolle spielt dabei die Krebsforschung.
Den Menschen im Mittelpunkt
Forschung und Wissenschaft müssen den Menschen im Mittelpunkt haben und dazu beitragen, das Leben besser zu machen. Diese Überzeugung vertrat der bildungs- und forschungspolitische Sprecher der CDU/CSU-Bundestagfraktion, Albert Rupprecht, in der Bundestagdebatte zu verschiedenen Berichten der Bundesregierung zu forschungs- und bildungspolitischen Programmen am Freitag. „Wenn wir Wohlstand und soziale Sicherheit auch in einer älter werdenden Gesellschaft aufrechterhalten wollen, dann geht das eben nur, indem wir die Produktivität steigern“, betonte Rupprecht. „Und Produktivitätssteigerung schaffen wir nur, indem wir auf Innovationen setzen.“ Deswegen sei die Verbesserung des Transfers von der Wissenschaft in Wirtschaft und Gesellschaft „eine der zentralen Schlüsselaufgaben“ der aktuellen Legislaturperiode.
Heute ging es im #Bundestag um das Thema #HighTech. Klare Worte dazu von @AnjaKarliczek: https://t.co/XXu0ARHdZ1 und @StefanKaufmann: https://t.co/d44cnGZvun .
Abonnieren Sie jetzt unseren NEWSLETTER ?:https://t.co/By30JnkXkipic.twitter.com/uWwURMbq35
— CDU/CSU (@cducsubt) 1. Februar 2019
„Wir wollen Krebs besser verstehen und verhindern"
Der Bundestag debattierte über die Berichte der Bundesregierung zur „Hightech-Strategie 2025 – Forschung und Innovation für die Menschen“ sowie zu den Rahmenprogrammen „Forschung für die zivile Sicherheit 2018-2023“ und „Quantentechnologien – von den Grundlagen zum Markt“. Bundesforschungsministerin Anja Karliczek nannte als besonders wichtiges Beispiel für einen verbesserten Transfer den Kampf gegen Krebs. Ziel müsse es sein, neue Therapien schneller aus der Forschung „ran ans Krankenbett“ zu bringen. „Wir wollen Krebs besser verstehen, wir wollen Krebs verhindern, wir wollen Krebs heilen“, so die Ministerin. Neben den Nationalen Zentren für Tumorerkrankungen in Heidelberg und Dresden sollen zusätzliche Standorte dieser Art aufgebaut werden, kündigte die Ministerin an. Als weitere Bereiche für einen besseren Transfer nannte Karliczek die Forschung zu Energiespeichern für Elektromobilität, den Aufbau einer Brennstoffzellen- und Batteriezellproduktion sowie die Forschung zu Künstlicher Intelligenz.
Einen starken europäischen Forschungsraum entwickeln
Der stellvertretende Vorsitzende Arbeitsgruppe Bildung und Forschung der Unionsfraktion, Stefan Kaufmann, sagte in der Debatte, der Forschungsstandort Deutschland werde „nur dann langfristig eine Perspektive haben und weltweit wettbewerbsfähig bleiben, wenn wir einen starken europäischen Forschungsraum entwickeln“. Deshalb sei es gut und richtig, dass Deutschland den noch von EU-Kommissar Günther Oettinger ausgearbeiteten mittelfristigen Finanzrahmen unterstütze, der auch deutliche Mehrausgaben für den Bereich der Forschung vorsehe. „Deutschland ist gut aufgestellt“, schloss Kaufmann. „Jetzt geht es darum, gemeinsam noch mehr Dynamik zu entfachen. Wir als Parlament tragen unseren Teil dazu bei.“






